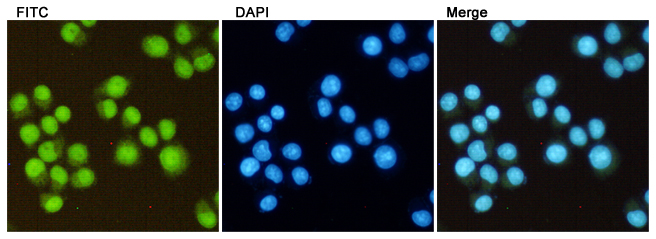

-
分类: 科研抗体货号: P20047别名: FN; Fibronectin; FN; Cold-insoluble globulin; CIG应用: WB,IHC,IF反应种属: Human
-
分类: 科研抗体货号: P20046别名: H3K27me2; H3 histone; HIST1H3A; Histone cluster 1; H3a应用: WB,IP,IF反应种属: Human,Mouse,Rat
-
分类: 科研抗体货号: P20075别名: PSEN1; AD3; PS1; PSNL1; Presenilin-1; PS-1; Protein S182应用: WB反应种属: Human
-
分类: 科研抗体货号: P20043别名: H3K27me3; H3 histone; HIST1H3A; Histone cluster 1; H3a应用: WB,IP,IHC,IF反应种属: Human,Rat
-
分类: 科研抗体货号: P20074别名: RPS6KA6; RSK4; Ribosomal protein S6 kinase alpha-6; S6K-alpha-6; 90 kDa ribosomal protein S6 kinase 6; p90-RSK 6; p90RSK6; Ribosomal S6 kinase 4; RSK-4; pp90RSK4应用: WB,IF反应种属: Human
-
分类: 科研抗体货号: P20037别名: H3K79me3; H3 histone; HIST1H3A; Histone cluster 1; H3a应用: WB,IP,IHC,IF反应种属: Human,Mouse,Rat
-
分类: 科研抗体货号: P20073别名: RPS6KA5; MSK1; Ribosomal protein S6 kinase alpha-5; S6K-alpha-5; 90 kDa ribosomal protein S6 kinase 5; Nuclear mitogen- and stress-activated protein kinase 1; RSK-like protein kinase; RSKL应用: WB,IP,IF反应种属: Human,Mouse,Rat,Hamster
-
分类: 科研抗体货号: P20033别名: CASP3; CPP32; Caspase-3; CASP-3; Apopain; Cysteine protease CPP32; CPP-32; Protein Yama; SREBP cleavage activity 1; SCA-1应用: WB反应种属: Human,Mouse
-
分类: 科研抗体货号: P20072别名: SYN1; Synapsin-1; Brain protein 4.1; Synapsin I应用: WB,IHC反应种属: Human,Rat
-
分类: 科研抗体货号: P20032别名: CASP3; CPP32; Caspase-3; CASP-3; Apopain; Cysteine protease CPP32; CPP-32; Protein Yama; SREBP cleavage activity 1; SCA-1应用: WB,IHC,IF反应种属: Human,Mouse,Rat

鄂公网安备42018502007531号
鄂公网安备42018502007531号

